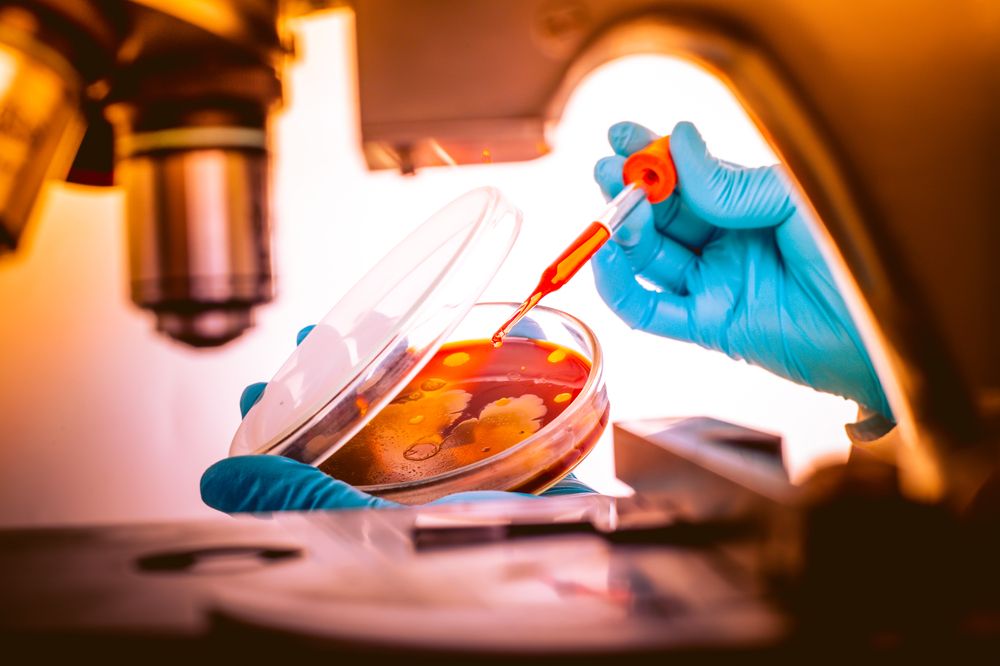

(Vienna, 07 May 2019) Working with their colleagues from the University of Lyon, researchers from MedUni Vienna's Center for Pathobiochemistry and Genetics have discovered mutations in genes that regulate the metabolic sensor mTOR in patients with familial sarcoidosis. The results of this new study have now been published in the "European Respiratory Journal". At the same time, a clinical trial is starting at MedUni Vienna’s Department of Dermatology to test the efficacy of mTOR inhibitors in the treatment of sarcoidosis.
Sarcoidosis is a disease in which nodules of immune cells form, primarily in the lungs but also in the skin or in the heart. While the lung symptoms are similar to those of tuberculosis, the aetiology of the disease is unknown. It is currently assumed that causation is multifactorial, whereby certain environmental impacts and bacterial pathogens trigger sarcoidosis in genetically predisposed individuals. For example, there was a rise in the number of cases of sarcoidosis among fireman who were deployed during 9/11, due to the enormous dust burden to which they were exposed. Also, the bacterium responsible for causing acne is found in the pulmonary granulomas of many patients.
Working with their colleagues Alain Calender and Yves Pacheco from Lyon, a research team led by Clarice Lim and Thomas Weichhart has now identified a genetic component that is involved in development of the disease. By conducting a genome analysis of families in which there are clusters of sarcoidosis, the study, which was published in the European Respiratory Journal, shows that the metabolic sensor mTOR plays a central role in the pathogenesis of sarcoidosis. In addition to this, the exome, which is the coded portion of the genome, of 22 people from 5 families was sequenced.
Says Weichhart: "The unique thing about the study design was that it allowed us to analyse patients and their unaffected siblings over three generations in some families. In this way we were able to identify mutations that were passed on exclusively to patients but not to their healthy relatives." Following detailed bioinformatic analysis, it was found that many mutations relate to genes that normally deactivate the metabolic sensor mTOR. Lead author Clarice Lim explains: "The mutations then result in mTOR being more active, so that these nodules, so-called granulomas, are more readily able to form."
Thomas Weichhart’s working group had already demonstrated in an animal model that the activation of mTOR in immune cells is sufficient to cause sarcoid granulomas to form. The new data now show that, on a genetic level as well, mTOR contributes to the development of sarcoidosis in patients.
Georg Stary from MedUni Vienna’s Department of Dermatology is currently conducting a clinical trial to test a therapeutic application of this relationship. A study funded by the Vienna Science and Technology Fund (WWTF) is to investigate the efficacy of the mTOR inhibitor Sirolimus in sarcoidosis patients with skin and pulmonary involvement. Sarcoidosis patients are still being sought for this clinical trial and an information event for patients will be held on 23 May 2019 starting at 18:30 hrs, with leading experts in sarcoidosis treatment and research at MedUni Vienna (interested parties should please email: georg.stary@meduniwien.ac.at).
The international sarcoidosis community is eagerly awaiting the results of the study, which, with the aid of the very latest molecular single-cell sequencing methods courtesy of Thomas Krausgruber from the CeMM, will provide new insights into the pathogenesis of sarcoidosis. But, most importantly, a new therapeutic option would benefit patients, since, in many cases, the available treatments for chronic sarcoidosis are less than adequate.
Service: European Respiratory Journal
Exome sequencing and pathogenicity-network analysis of 5 French families implicate mTOR signalling and autophagy in familial sarcoidosis. Alain Calender*, Clarice X. Lim*, Thomas Weichhart, Adrien Buisson, Valérie Besnard, Pierre Antoine Rollat-Farnier, Claire Bardel, Pascal Roy, Vincent Cottin, Gilles Devouassoux, Amélie Finat, Stéphane Pinson, Serge Lebecque, Hilario Nunes, Dominique Israel-Biet, Abderazzaq Bentaher, Dominique Valeyre, and Yves Pacheco, in the frame of GSF (Group Sarcoidosis France). doi.org/10.1183/13993003.00430-2019